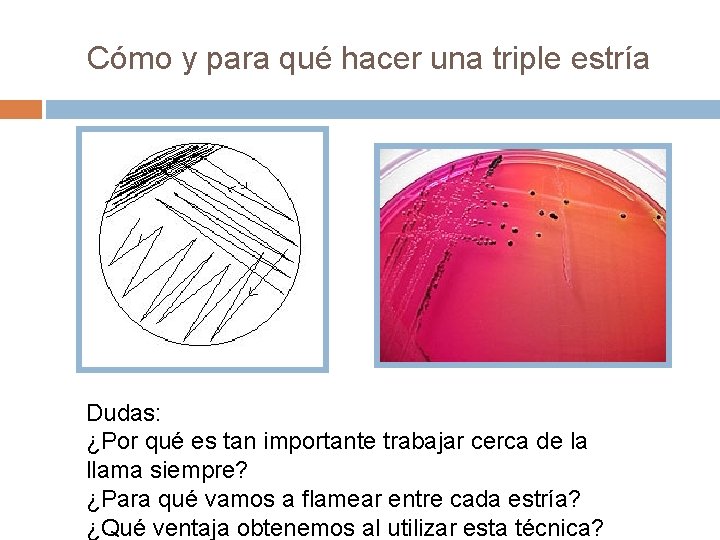
Cómo y para qué hacer una triple estría Dudas: ¿Por qué es tan importante

MEDIOS DE CULTIVO II David Agud y Luz

- Slides: 7
MEDIOS DE CULTIVO II David Agud y Luz Martínez
Ahora la memoria la hacéis vosotros!!! Título de la práctica Nombre y Apellidos Introducción teórica que remarque se pretende con la práctica Materiales que utilizaremos Desarrollo de la práctica Conclusiones 3 cuestiones que haríais a los alumnos
Resumen Ø Ø Hemos obtenido bacterias del medio ambiente de diferentes formas: Poniendo el dedo sobre la superficie del medio de cultivo. Recogiéndolas mediante bastoncillos de algodón.
Vamos a teñir una colonia de bacterias y a observarlas al microscopio óptico Haremos una triple estría ¿Para qué?
Cómo y para qué hacer una triple estría Dudas: ¿Por qué es tan importante trabajar cerca de la llama siempre? ¿Para qué vamos a flamear entre cada estría? ¿Qué ventaja obtenemos al utilizar esta técnica?
Tinción de bacterias 1. 2. 3. 4. 5. Colocad una o dos gotas de agua en un extremo del porta. Recoged con el asa de siembra una colonia de bacterias y diluidla en la gota de agua. Haced un frotis a lo largo de todo el porta. Flamead un par de veces el porta con el mechero sin dejarlo encima para no quemar la muestra ¿Para qué haremos esto? Colocad el porta sobre la bandeja de tinción y echad una o dos gotas de colorante azul de metileno, safranina o cristal violeta. 6. Esperad un minuto. 7. Inclinad el porta y enjuagad con agua de forma delicada. 8. Secad el porta moviéndolo con la mano. 9. Observad las bacterias al microscopio. Recordad que se comienza a observar con el objetivo (lente) de menor aumento, esto es 4 X, luego con los siguientes objetivos y por ultimo el de 100 X, con el cual utilizarían aceite de inmersión.
ahora a trabajar!!